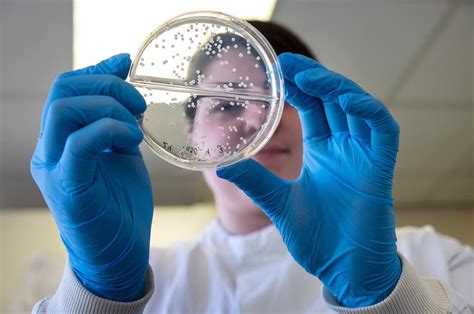

NovaBiotics Aberdeen: Breakthroughs In Biotech
NovaBiotics Aberdeen: Your Guide to Biotech Breakthroughs
Hey everyone! Today, we’re diving deep into the world of NovaBiotics , a seriously cool biotech company making waves right here in Aberdeen . If you’re into innovative science, cutting-edge drug development, and companies that are genuinely trying to make a difference in people’s health, then stick around. NovaBiotics isn’t just another lab; they’re pioneers in developing novel treatments for a whole range of challenging conditions. We’re going to explore what makes them tick, their groundbreaking work, and why Aberdeen is the perfect hub for their ambitious goals. Get ready to be impressed, guys!
Table of Contents
The NovaBiotics Story: From Vision to Reality
So, what’s the big deal about NovaBiotics ? At its core, this Aberdeen-based biotech firm is all about novel anti-infective and immune therapies . Founded with a vision to tackle unmet medical needs, they’ve built a reputation for their rigorous scientific approach and their commitment to translating complex research into tangible treatments. Think about diseases that are notoriously tough to treat, like cystic fibrosis-related lung infections, or conditions that affect millions globally, such as fungal infections and inflammatory skin diseases. NovaBiotics is in the trenches, working tirelessly on solutions. Their journey started with a clear mission: to leverage a deep understanding of microbial and immune pathways to create therapies that are not only effective but also have a favorable safety profile. This isn’t just about finding a cure; it’s about improving the quality of life for patients who often have limited options. The company has a rich pipeline of drug candidates, each backed by substantial research and development. They focus on areas where there’s a significant disease burden and a clear need for innovation. This strategic focus allows them to concentrate their expertise and resources on developing therapies that have the potential for maximum impact. It’s this dedication to solving complex health challenges that really sets NovaBiotics apart in the crowded biotech landscape. Their work is crucial, especially in an era where antibiotic resistance is a growing global concern. Finding new ways to combat infections is no longer just a scientific pursuit; it’s a public health imperative.
The Science Behind the Success
Let’s get a little nerdy for a sec, shall we? The scientific innovation at NovaBiotics is truly fascinating. They’re not just rehashing old ideas; they’re developing entirely new ways to fight disease. A major area of their focus is on antifungal therapies . Fungal infections, especially invasive ones, can be life-threatening, particularly for individuals with weakened immune systems. NovaBiotics has developed compounds that show remarkable efficacy against a broad spectrum of fungi, including those that have developed resistance to existing treatments. This is HUGE, guys! Their lead antifungal candidate, for instance, targets a crucial component of the fungal cell wall, a mechanism that is distinct from many current antifungal drugs. This distinct mechanism is key to overcoming resistance and providing a much-needed alternative for patients. Beyond antifungals, they’re also making significant strides in inflammatory and autoimmune diseases . Conditions like hidradenitis suppurativa (HS), a chronic and painful skin condition, are areas where NovaBiotics is developing novel therapies. HS is often misunderstood and undertreated, leaving patients with significant physical and emotional distress. NovaBiotics’ approach here involves modulating the immune response to reduce inflammation and improve skin health. They utilize a deep understanding of the inflammatory cascade to design molecules that can precisely target the pathways responsible for the disease. This targeted approach aims to minimize side effects often associated with broader immunosuppressive therapies. The drug discovery and development process at NovaBiotics is incredibly robust. They employ state-of-the-art techniques in molecular biology, microbiology, and pharmacology. Their R&D team is composed of highly skilled scientists with diverse expertise, fostering an environment of collaboration and continuous learning. From initial compound screening to preclinical testing and clinical trials, every step is meticulously planned and executed. This commitment to research excellence ensures that their drug candidates are thoroughly vetted before moving into human studies, increasing the likelihood of success and ultimately benefiting patients faster. It’s this blend of scientific rigor and creative problem-solving that really makes NovaBiotics a standout player in the Aberdeen biotech scene and beyond.
Spotlight on Key Therapies
Now, let’s shine a light on some of the specific therapies that NovaBiotics is working on. It’s where the rubber meets the road, right? One of their most talked-about developments is in the realm of cystic fibrosis (CF) . CF is a genetic disorder that causes severe damage to the lungs, digestive system, and other organs. A major complication for CF patients is recurrent lung infections, often caused by bacteria like Pseudomonas aeruginosa . NovaBiotics has developed a novel approach using a potent antimicrobial peptide, which has shown promise in penetrating the thick mucus in CF lungs and directly combating these stubborn infections. This is a game-changer because many existing antibiotics struggle to reach effective concentrations within the CF lung environment. Their compound is designed to be delivered directly to the lungs, offering a localized and targeted treatment. The potential to reduce the frequency and severity of lung infections could dramatically improve the lives of CF patients, offering them a better chance at a healthier future. Another significant area is their work on fungal infections , particularly those affecting the nails and skin. Onychomycosis (nail fungus) and dermatophytosis (skin fungus) are incredibly common but notoriously difficult to treat effectively, especially with oral medications that can have systemic side effects. NovaBiotics is developing topical formulations that deliver their potent antifungal compounds directly to the site of infection. This localized approach not only enhances efficacy but also minimizes the risk of adverse reactions, making it a much more appealing treatment option for patients and healthcare providers alike. Their drug pipeline is diverse, reflecting their broad capabilities in targeting various disease mechanisms. They’re not putting all their eggs in one basket, which is smart! This diversified approach allows them to explore multiple avenues for innovation and to address a wider range of patient needs. Each project is driven by a deep understanding of the underlying disease biology and a commitment to developing differentiated therapies that can offer a real advantage over existing treatments. The company’s progress in these areas is a testament to their scientific expertise and their strategic vision for addressing significant global health challenges. It’s exciting stuff, folks, and it highlights the critical role that biotech companies like NovaBiotics play in advancing medical science.
Aberdeen: A Hub for Biotech Innovation
Why Aberdeen , you ask? Well, this city is proving to be a surprisingly fertile ground for biotech and life sciences. NovaBiotics is a prime example of the kind of innovative company that thrives here. Aberdeen has a strong heritage in research and development, particularly stemming from its links to the energy sector, which has fostered a culture of technological advancement and problem-solving. The city boasts excellent universities and research institutions, creating a rich talent pool and opportunities for collaboration. Think of the University of Aberdeen and Robert Gordon University – they are hubs of scientific discovery and provide skilled graduates who can fuel the growth of companies like NovaBiotics. Furthermore, the Scottish government and local enterprise agencies are actively supporting the growth of the life sciences sector, offering funding, infrastructure, and networking opportunities. This supportive ecosystem is crucial for biotech startups and established firms alike. It helps bridge the gap between groundbreaking research and commercial success. NovaBiotics has benefited from this environment, allowing them to focus on their core mission of developing life-changing therapies. The presence of other science-focused businesses and a growing network of investors interested in the sector also creates a dynamic and collaborative atmosphere. It’s not just about individual companies; it’s about building a cluster of expertise that can drive collective progress. The infrastructure in Aberdeen, including dedicated science parks and business incubators, provides the necessary facilities for research and development. This allows companies to scale their operations efficiently and effectively. The Aberdeen biotech scene is vibrant and growing, and NovaBiotics is undoubtedly one of its shining stars. It demonstrates that cutting-edge biotechnology can flourish outside the traditional hubs, bringing economic benefits and improving health outcomes for people worldwide. The city’s strategic location and connectivity also play a role, making it accessible for partnerships and collaborations. It’s this combination of academic excellence, government support, and a forward-thinking approach that makes Aberdeen a truly exciting place for biotech innovation .
The Future Looks Bright
Looking ahead, the future for NovaBiotics is incredibly promising. With a robust pipeline of novel therapies and a strong scientific foundation, the company is well-positioned to make significant contributions to healthcare. Their ongoing clinical trials are closely watched by the medical community, and the results so far have been encouraging. The potential for their treatments to address serious unmet medical needs means that their success would not only be a win for the company but, more importantly, a win for countless patients worldwide. The biotech industry is constantly evolving, and companies that can innovate and adapt are the ones that will lead the way. NovaBiotics’ focus on developing differentiated therapies with clear advantages over existing treatments places them at the forefront of this evolution. Their commitment to tackling challenging diseases like invasive fungal infections and chronic inflammatory conditions demonstrates a dedication to improving patient outcomes where it’s needed most. As they continue to advance their drug candidates through the development process, partnerships and collaborations will likely play an increasingly important role. Engaging with larger pharmaceutical companies or forming strategic alliances can help accelerate the development and commercialization of their therapies, bringing them to patients even faster. The supportive environment in Aberdeen will also continue to be a factor in their growth, providing access to talent, funding, and research infrastructure. It’s this combination of internal drive and external support that fuels their progress. Ultimately, the success of NovaBiotics in Aberdeen represents more than just a business venture; it signifies hope for patients suffering from debilitating diseases and showcases the power of scientific innovation to transform lives. The journey is far from over, but the trajectory is exciting, and the potential impact is immense. Keep an eye on this Aberdeen biotech powerhouse – they are doing amazing things!
Conclusion: A Beacon of Hope
In conclusion, NovaBiotics stands out as a truly remarkable biotech company based in Aberdeen . Their dedication to developing novel anti-infective and immune therapies addresses critical unmet medical needs across a range of challenging conditions. From tackling drug-resistant fungal infections to pioneering new treatments for inflammatory diseases and cystic fibrosis complications, NovaBiotics is at the cutting edge of medical innovation. Their rigorous scientific approach, coupled with a strategic focus on areas with significant patient impact, positions them as a key player in the global biopharmaceutical landscape . The vibrant biotech ecosystem in Aberdeen , with its strong research institutions and supportive infrastructure, provides an ideal environment for NovaBiotics to thrive and grow. As they continue to advance their promising drug pipeline through clinical development, the future looks exceptionally bright . NovaBiotics isn’t just developing drugs; they are creating hope for patients and offering solutions where few exist. They are a testament to the power of scientific ingenuity and the potential for Aberdeen to be a hub for world-class biotechnology . Keep watching this space, folks – NovaBiotics is definitely a company to be excited about!